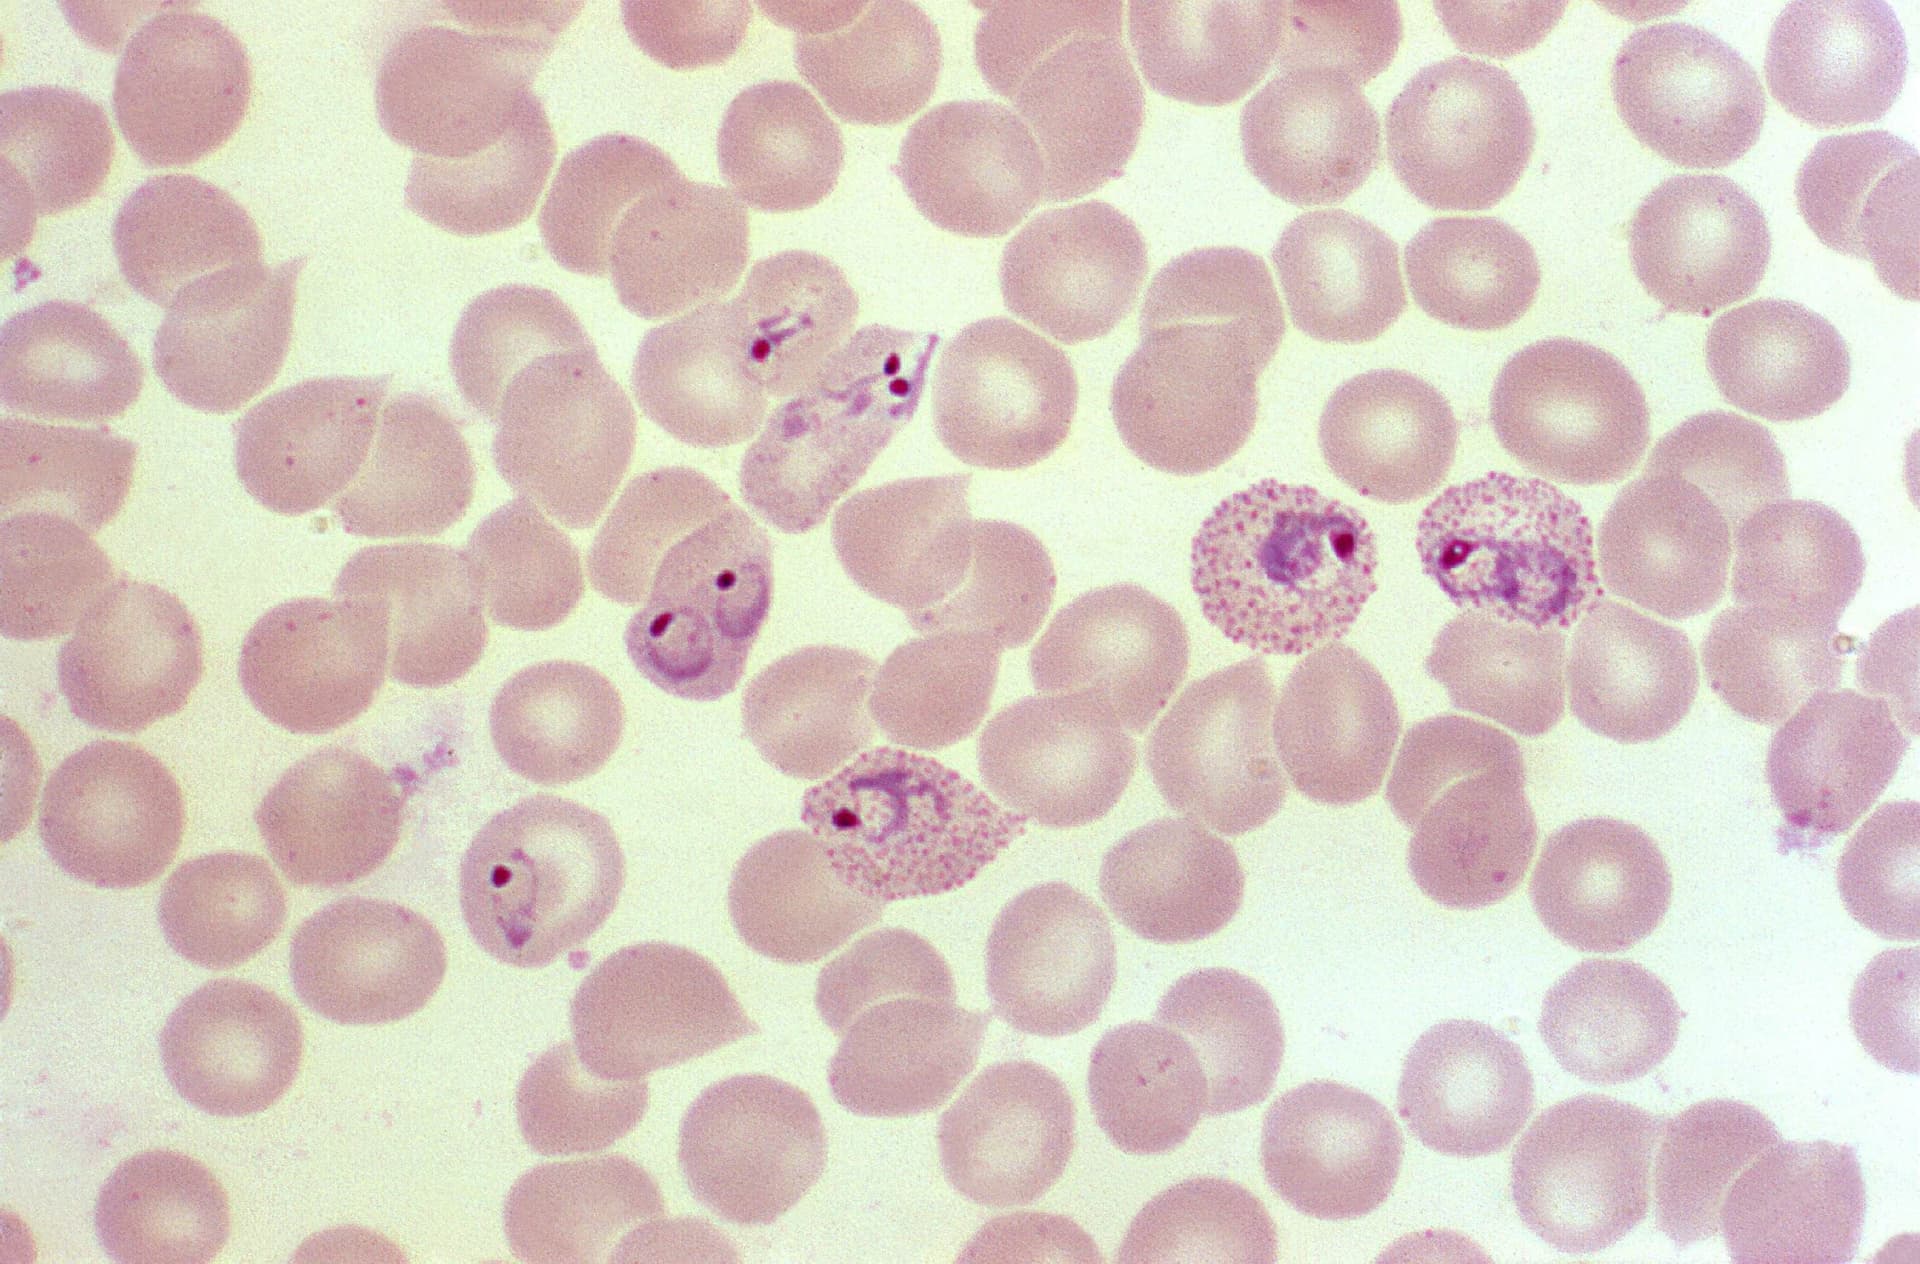
Ky sinh trung 2.jpg

XÉT NGHIỆM TÌM KÝ SINH TRÙNG SỐT RÉT TRONG MÁU
| STT | NỘI DUNG | MINH HỌA |
| 1. | Tiêu đề | Xét nghiệm tìm ký sinh trùng sốt rét trong máu |
| 2. | Giới thiệu tóm tắt về xét nghiệm, kĩ thuật | - Kí sinh trùng sốt rét được tìm thấy bằng cách soi giọt máu đặc hoặc giọt máu đàn trên kính hiển vi. Giọt máu được nhuộm bằng Giemsa loãng. |
| 3. | Định nghĩa, vai trò, nguyên lý, giá trị của xét nghiệm, kĩ thuật |
|
| 4. | Đối tượng cần làm xét nghiệm | Người bệnh có biểu hiện lâm sàng nghi ngờ nhiễm ký sinh trùng sốt rét; Người bệnh đã và đang sinh sống ở vùng có sốt rét lưu hành; Người bệnh mới từ vùng sốt rét trở về. |
| 5. | Quy trình thực hiện xét nghiệm | 1. Làm tiêu bản giọt đặc: - Dùng pipet hút 1 giọt máu có đường kính 3mm ở chính giữa lam - Dùng góc 1 lam kính sạch khác đặt vào trung tâm của giọt máu đánh theo đường xoắn ốc từ trong ra ngoài khoảng 5- 6 vòng để được giọt máu có đường kính 0,9- 1,0cm. 2. Làm tiêu bản giọt máu đàn: - Dùng pipet hút 1 giọt máu có đường kính 1mm ở 2/3 lam kính. - Đặt cạnh của lam kéo lên phía trước sát với giọt máu tạo thành góc 30- 45o, lùi lam kéo về phía sau một chút để máu lan đều trên cạnh của lam kéo, đẩy nhanh lam kéo về phía trước, để khô tự nhiên. Xếp tiêu bản lên giá Để khô tự nhiên hoặc sấy mát bằng quạt sấy. Chuẩn bị 2 cóng giemsa: - Thì 1: giemsa nguyên chất - Thì 2: giemsa pha loãng tỷ lệ 1/5(1 giemsa nguyên chất: 4 nước cất) 3. Cố định tiêu bản *. Giọt đặc: - Không cố định. - Đối với những trường hợp giọt đặc quá dầy hay bẩn mốc thì phải dung giải bằng cách nhỏ nước cất hay Giemsa 1% trong 1- 2 phút, đổ nước, cắm lên giá, hong khô. *. Giọt đàn: - Nhỏ cồn tuyệt đối dàn đều tiêu bản. - Để khô tự nhiên. 4. Nhuộm tiêu bản. - Nhuộm giemsa 2 thì: thì 1 bằng giemsa nguyên chất trong 7 giây sau đó rửa bằng nước sạch; tiếp đến nhuộm thì 2 bằng giemsa pha loãng trong 7 phút. - Rửa tiêu bản bằng nước sạch, xếp tiêu bản lên giá sạch và sấy khô.
|
| 6. | Xét nghiệm ở đâu uy tín chất lượng? | Bệnh viện Phổi trung ương là đơn vị y tế uy tín hiện nay khi thực hiện xét nghiệm này. Mọi vấn đề cần tư vấn liên quan đến xét nghiệm tìm ký sinh trùng sốt rét trong máu bạn đọc có thể gọi ngay cho tổng đài 1900 3463 để được đội ngũ chuyên gia y tế của Bệnh viện Phổi Trung ương chia sẻ những thông tin xác đáng |
| 7. | Tài liệu tham khảo (Chọn lựa những tài liệu chính thống của BYT, chuyên ngành, ….) | - Quyết định số 4401/QĐ-BYT ngày 09 tháng 11 năm 2012 của Bộ trưởng Bộ Y Tế, về danh mục 71 Quy trình kỹ thuật khám bệnh, chữa bệnh chuyên ngành Huyết học- Truyền máu- Miễn dịch-Di truyền. - Kỹ thuật xét nghiệm huyết học và truyền máu ứng dụng trong lâm sàng. Nhà xuất bản Y học, Hà Nội 2013. - Bệnh học nội khoa (2012), Nhà xuất bản Y học. |
Trưởng khoa
|